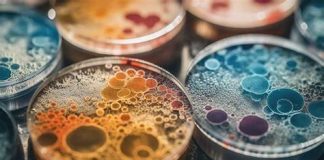

Microbes du passé: La science remonte le temps pour percer les mystères de la peste et de la lèpre
Pourquoi les épidémies de peste ont-elles duré si longtemps ? La lèpre existait-elle déjà en Amérique avant l’arrivée des Européens ? Pour répondre à ces deux grandes questions, des chercheurs ont mené un véritable travail d’archéologie microbienne, analysant des bactéries parfois vieilles de plusieurs millénaires. Deux études sur l’histoire de ces maladies emblématiques viennent d’être … Lire la suite de Microbes du passé: La science remonte le temps pour percer les mystères de la peste et de la lèpre
0 Commentaire